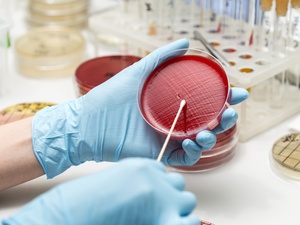

Desmatamento eleva casos de malária e outras doenças infecciosas

O desmatamento é um dos principais problemas ambientais do mundo. No Brasil, é um desafio histórico e difícil de ser controlado. Segundo o INPE (Instituto Nacional de Pesquisas Espaciais), em maio deste ano o desflorestamento na Amazônia cresceu 34% em comparação ao mesmo mês em 2019.
Além do prejuízo para o meio ambiente, a derrubada das matas também está relacionada a origem de várias doenças, especialmente as infecciosas. Buscando mostrar essa conexão, um estudo conduzido por cientistas da FSP-USP (Faculdade de Saúde Pública da Universidade de São Paulo), divulgado recentemente na renomada Revista Nature, demonstra o efeito dessa cadeia no crescimento da malária - doença infecciosa causada pelo protozoário Plasmodium, transmitido pelo mosquito Anopheles. Caracterizada por febre, vômitos, dores e tremores, em casos graves pode levar à morte. Segundo o Ministério da Saúde, já foram registrados 31 mil casos no Brasil, apenas no primeiro trimestre do ano e 157 mil em 2019.
De acordo com a pesquisa, realizada entre os anos 2010 e 2020, áreas nas quais há produção e retirada de commodities como madeira, café e tabaco são responsáveis por 20% do risco de surgimento da doença. "Diversas perturbações ambientais, como o desmatamento e a instalação de pessoas nessas áreas criam o habitat ideal para o mosquito", afirma Leonardo Suveges, doutor em ciências pela FSP-USP e um dos autores do artigo. O processo desordenado de ocupação da terra e a urbanização precária são fatores que promovem as condições ideais para a transmissão de micro-organismos que têm como hospedeiros animais das florestas.
Os pesquisadores se basearam em informações do levantamento realizado na Universidade de Sydney, na Austrália, sob a condução de Manfred Lenzen, professor de Análise Integrada de Sustentabilidade. Os australianos cruzaram dados das rotas comerciais dos mais importantes fornecedores das commodities, taxas de desmatamento e índices da enfermidade.
Foi a primeira vez que um estudo traçou a relação entre a compra de commodities por países desenvolvidos e o aumento nos números de casos de malária. Dez nações - Alemanha, Estados Unidos, Reino Unido, Japão, China, Itália, França, Espanha, Bélgica e Países Baixos - dividem 10% da responsabilidade do risco de aparecimento de malária causado pelo desmatamento. Ao todo, dez milhões de pessoas, especialmente na África Subsaariana, estão vulneráveis.
Segundo o trabalho, os países mais afetados são a Nigéria - onde, em 2015, 6 milhões de casos de malária estavam relacionados ao desflorestamento - e a Tanzânia, onde 5,6 milhões de pessoas tiveram a doença porque habitavam locais próximos às áreas desmatadas. O Brasil não aparece entre os países que mais sofrem da doença devido à exploração de commodities.
Entre as nações ricas que mais contribuíram para a doença, segundo dados das importações de commodities de 2015, a China é a líder, sendo responsabilizada por 1,7 milhão de casos. A Alemanha vem em segundo, com 1,5 milhão, e o Japão, com 986 mil, completam o pódio.
Malária no Brasil
No país, a malária está presente quase em sua totalidade na região amazônica - seis dos sete estados da região já apresentaram mais de mil casos somente no primeiro trimestre do ano. Condições climáticas, ambientais e sociais fazem com que a região esteja mais suscetível à enfermidade. Uma pesquisa da Universidade Stanford, nos Estados Unidos, indica que a cada quilômetro desmatado na Amazônia, seis novos casos surgem na região.
Além da malária, o desflorestamento é responsável por outras doenças como a leishmaniose e febre amarela. Um estudo, feito para o desenvolvimento do Relatório de Biodiversidade das Organizações das Nações Unidas (ONU) de 2018, analisou 15 mil pesquisas sobre o assunto e concluiu que o desmatamento, assim como a monocultura, pecuária e mineração facilitam o surgimento de novas doenças infecciosas e epidêmicas.

ID: {{comments.info.id}}
URL: {{comments.info.url}}
Ocorreu um erro ao carregar os comentários.
Por favor, tente novamente mais tarde.
{{comments.total}} Comentário
{{comments.total}} Comentários
Seja o primeiro a comentar
Essa discussão está encerrada
Não é possivel enviar novos comentários.
Essa área é exclusiva para você, assinante, ler e comentar.
Só assinantes do UOL podem comentar
Ainda não é assinante? Assine já.
Se você já é assinante do UOL, faça seu login.
O autor da mensagem, e não o UOL, é o responsável pelo comentário. Reserve um tempo para ler as Regras de Uso para comentários.